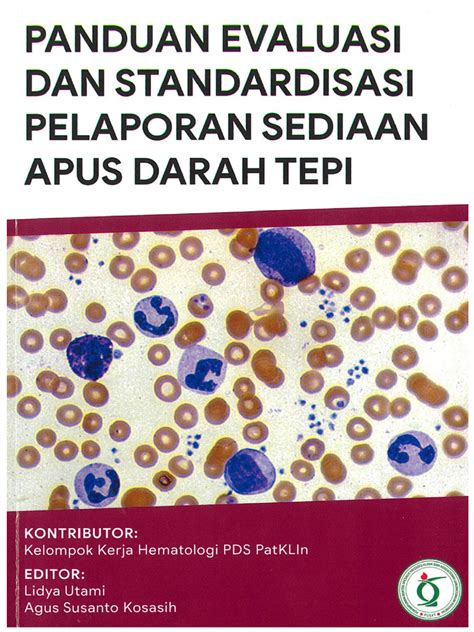

Jalan Oscar Bambu Apus: Panduan Lengkap
Jalan Oscar Bambu Apus: Panduan Lengkap
Hey guys, let’s dive deep into Jalan Oscar Bambu Apus ! If you’re looking for information about this specific location, you’ve come to the right place. We’re going to break down everything you need to know, from its history and significance to what you can expect when you visit. Whether you’re a local, a tourist, or just curious, this guide is packed with details to make your exploration of Jalan Oscar Bambu Apus a breeze. Get ready to discover the unique charm and hidden gems of this interesting street!
Table of Contents
Sejarah dan Signifikansi Jalan Oscar Bambu Apus
Let’s rewind and explore the rich history and significance of Jalan Oscar Bambu Apus . This isn’t just any street; it’s a place with a story. Understanding its past can really enhance your appreciation of the area. So, what’s the deal with Oscar Bambu Apus? The name itself might spark some curiosity. ‘Bambu Apus’ refers to a specific type of bamboo, often found in Indonesia, known for its strong yet flexible properties. This suggests that historically, this area might have been rich in this natural resource, perhaps influencing its early development and economy. Was it a hub for bamboo crafts, or did the dense bamboo forests shape the landscape and settlement patterns? These are the kinds of questions that unlock the street’s deeper narrative. The ‘Oscar’ part of the name could point to a person, perhaps a prominent figure, a landowner, or even a developer who played a key role in the area’s early days. Sometimes street names are dedicated to honor individuals who contributed significantly to the community, and knowing who Oscar was could offer fascinating insights into the local heritage.
Furthermore, the strategic location of Jalan Oscar Bambu Apus might have contributed to its historical importance. Was it a crucial route for trade, connecting different settlements or resources? Was it situated near important landmarks, administrative centers, or natural attractions that drew people to the area? Historical maps and local archives could reveal whether this street served as a vital artery in the past. Think about the evolution of the surrounding neighborhoods too. How did Jalan Oscar Bambu Apus develop alongside them? Did it grow from a small track into a bustling thoroughfare, or was it planned from the outset? The architectural styles of older buildings along the street, if any, can also be a visual testament to different eras and influences. It’s like peeling back layers of time , each element telling a part of the street’s grander story. Understanding this historical context transforms a simple street name into a portal to the past, revealing the forces that shaped its identity and its people. We’ll delve into any available records or local lore to paint a comprehensive picture of Jalan Oscar Bambu Apus’s journey through time, highlighting its enduring significance in the present day.
Menjelajahi Area Sekitar Jalan Oscar Bambu Apus
Alright guys, now that we’ve touched upon the history, let’s get to the fun part: exploring the area around Jalan Oscar Bambu Apus ! This is where you get to experience the vibe of the place firsthand. What makes this neighborhood tick? Think about the local businesses, the eateries, the green spaces, and the general atmosphere. Are there any hidden cafes serving up the best coffee you’ve ever tasted? Perhaps some unique boutiques offering handcrafted goods? Or maybe some bustling markets where you can find fresh produce and local delicacies? Exploring these spots is what truly brings a place to life.
One of the first things to consider is the accessibility and transportation options. How easy is it to get to Jalan Oscar Bambu Apus? Are there major roads nearby? Is it well-served by public transport like buses or trains? This information is super handy for anyone planning a visit. Knowing the best ways to navigate the area will save you time and hassle, allowing you to focus on enjoying your exploration.
Next up, let’s talk about amenities and facilities . What kind of conveniences are available for residents and visitors? Are there parks for a leisurely stroll or some playtime? Are there educational institutions, healthcare facilities, or community centers that serve the neighborhood? The presence and quality of these amenities can tell you a lot about the lifestyle and community spirit of the area. For example, a well-maintained park suggests a community that values outdoor activities and recreation, while proximity to good schools might indicate a family-friendly environment.
Don’t forget to check out the cultural and recreational activities ! Are there any local attractions, historical sites, or event venues nearby? Perhaps there are art galleries, museums, or performance spaces that offer a glimpse into the local culture. Even small community events or festivals can be a great way to experience the authentic flavor of the neighborhood. Immerse yourself in the local scene , and you might discover something truly special.
Finally, let’s consider the residential aspects . What kind of housing is prevalent in the area? Is it a mix of landed houses and apartments, or is one type more dominant? Understanding the housing landscape can give you a sense of the community’s demographics and lifestyle. Is it a quiet residential area perfect for families, or is it a vibrant hub with a mix of residents? By looking at these elements – accessibility, amenities, cultural offerings, and residential characteristics – we can build a vivid picture of what it’s like to be around Jalan Oscar Bambu Apus. So, lace up your walking shoes, grab your curiosity, and let’s go discover all the surrounding wonders!
Fasilitas dan Keunggulan Jalan Oscar Bambu Apus
Now, let’s zoom in on the specific facilities and advantages that Jalan Oscar Bambu Apus offers . Why might this particular street stand out? What makes it a desirable place to live, work, or visit? We’re talking about the tangible benefits and unique selling points that contribute to its appeal. Think of it as the street’s ‘highlight reel’.
First and foremost, let’s consider the strategic location and connectivity . Being well-connected is a huge plus for any area. Is Jalan Oscar Bambu Apus situated close to major transportation hubs, highways, or business districts? Its proximity to key areas can significantly reduce commute times and make it easier to access essential services and recreational activities. A prime location often means convenience , and convenience is something we all value, right? Whether it’s a short drive to a shopping mall, a quick hop to the airport, or easy access to public transit, good connectivity is a major advantage.
Next, let’s talk about the availability of essential amenities . What kind of facilities are readily accessible to people on Jalan Oscar Bambu Apus? This could include anything from supermarkets and banks to post offices and pharmacies. Having these services within easy reach makes daily life much smoother. Imagine not having to travel far for your groceries or to handle your banking needs – that’s a real quality-of-life improvement.
Consider also the presence of educational and healthcare institutions . For families, proximity to good schools is often a top priority. Similarly, access to reliable healthcare services, such as clinics or hospitals, provides peace of mind. The availability of these vital institutions can make an area highly attractive to a wide range of residents.
What about recreational and leisure opportunities ? Are there parks, sports facilities, or community centers nearby? Opportunities for relaxation and recreation are crucial for a balanced lifestyle. Perhaps there are local eateries, entertainment venues, or cultural spots that add to the neighborhood’s vibrancy. These leisure options contribute to a well-rounded living experience .
Finally, let’s not overlook the commercial potential and economic activity . Is Jalan Oscar Bambu Apus a place where businesses thrive? Is it a hub for certain industries or services? The presence of a dynamic commercial environment can indicate economic vitality and create job opportunities for the local population. It might also mean a lively street scene with plenty of places to eat, shop, and socialize.
By examining these facilities and advantages – from its strategic positioning and essential services to its recreational offerings and economic prospects – we can truly appreciate what makes Jalan Oscar Bambu Apus a notable location. It’s these combined elements that create a desirable and functional environment for everyone involved.
Tips untuk Mengunjungi atau Tinggal di Jalan Oscar Bambu Apus
So, you’re thinking about visiting or maybe even settling down in Jalan Oscar Bambu Apus ? Awesome! To make your experience the best it can be, here are some top tips for visiting or living here. We want you to feel right at home, or at least have a fantastic time exploring. Let’s get you prepped!
Tips untuk Pengunjung
If you’re just popping in for a visit, here’s the lowdown:
- Plan Your Route: Before you head out, do a quick check on the best ways to get there. Use navigation apps, check public transport schedules, or ask a local if you’re unsure. Getting there smoothly sets a positive tone for your visit. Is there ample parking if you’re driving? Knowing these details in advance can save you a lot of stress.
- Explore During Daylight Hours: While safety is generally a concern everywhere, exploring new areas during the day is always a good idea. You can better appreciate the surroundings, find landmarks easily, and feel more comfortable navigating. Daylight exploration offers the best views and opportunities for discovery.
- Engage with Locals: Don’t be shy! Locals often have the best insider tips on hidden gems, great food spots, or interesting things to see that aren’t in the guidebooks. A friendly chat can lead to memorable experiences. Locals are your best resource for authentic experiences .
- Try the Local Cuisine: If there are eateries around Jalan Oscar Bambu Apus, make sure to sample some local flavors. Food is a huge part of culture, and you might find your new favorite dish!
- Respect the Environment and Culture: Be mindful of local customs and traditions. Keep the area clean, dispose of trash properly, and be respectful of private property. A little respect goes a long way in ensuring a positive interaction.
Tips untuk Penduduk
Thinking of making Jalan Oscar Bambu Apus your home base? Smart move! Here’s how to settle in:
- Connect with Your Neighbors: Building good relationships with people on your street is key to feeling at home. Introduce yourself, join local community groups, or participate in neighborhood events. A strong community network enhances your living experience .
- Stay Informed About Local Developments: Keep up-to-date with any local news, community meetings, or development plans. Being informed helps you stay involved and have a say in your neighborhood’s future.
- Utilize Local Facilities: Make the most of the amenities available – parks, community centers, libraries, etc. They are there for you to enjoy and benefit from. Local facilities are community assets .
- Support Local Businesses: Shopping and dining locally not only helps the neighborhood economy but also fosters a sense of community. You’ll often find unique products and personalized service.
- Contribute to the Community: Whether it’s volunteering, participating in clean-up drives, or simply being a considerate neighbor, contributing positively makes Jalan Oscar Bambu Apus an even better place to live for everyone. Your contribution matters !
By following these tips, both visitors and residents can truly make the most of their time and experience at Jalan Oscar Bambu Apus. Happy exploring and settling in, guys!